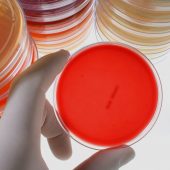

O Portal EadPLUS firma parceria com as empresas Formato Clínico e You Care. Agora, o Portal EadPlus oferece cursos no segmento Medicina Diagnóstica, que engloba Análises Clínicas e diagnóstico por imagem, e Gestão na Área de Saúde Privada.
Especializadas no segmento da saúde, as empresas Formato Clínico e You Care são focadas em apoiar o crescimento de empresas do setor para melhorar o valor entregue aos pacientes. Qualidade, segurança do paciente, desenvolvimento de áreas técnicas, planos estratégicos e de marketing, incorporação de novas tecnologias e desenvolvimento de equipe de alta performance, são alguns dos temas que farão parte do portfólio de cursos desta parceria.
 |
Para que você possa conhecer um pouco mais desta parceria, preparamos uma entrevista exclusiva com as diretoras da Formato Clínico e You Care junto ao presidente do Portal EaDPLUS.
|
Conheça os Novos Cursos Disponíveis
|
|
|